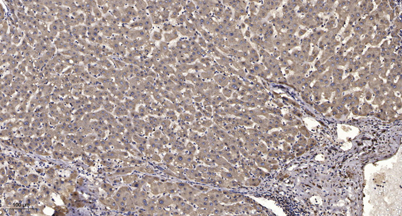

ITIH6 rabbit pAb
 One-click to copy product information
One-click to copy product information$148.00/50µL $248.00/100µL
| 50 µL | $148.00 |
| 100 µL | $248.00 |
Overview
| Product name: | ITIH6 rabbit pAb |
| Reactivity: | Human;Rat;Mouse; |
| Source: | Rabbit |
| Dilutions: | WB 1:500-2000;IHC-p 1:50-300; ELISA 2000-20000 |
| Immunogen: | Synthesized peptide derived from human ITIH6 AA range: 152-202 |
| Storage: | -20°C/1 year |
| Clonality: | Polyclonal |
| Isotype: | IgG |
| Concentration: | 1 mg/ml |
| Molecular Weight: | 144kD |
| GeneID: | 347365 |
| Human Swiss-Prot No: | Q6UXX5 |
| Cellular localization: | Secreted . |
| Background: | The protein encoded by this gene belongs to the interalpha trypsin inhibitor heavy chain (ITIH) family. Interalpha trypsin inhibitor (ITI) is composed of two heavy chains (containing VWA domain) and one light chain. The light chain confers the protease-inhibitor function, while the heavy chains are involved in mediating protein-protein interactions with the components of the extracellular matrix. [provided by RefSeq, Sep 2009], |
-
 Western blot analysis of lysates from U2OS cells, primary antibody was diluted at 1:1000, 4°over night
Western blot analysis of lysates from U2OS cells, primary antibody was diluted at 1:1000, 4°over night -
Immunohistochemical analysis of paraffin-embedded human liver cancer. 1, Antibody was diluted at 1:200(4° overnight). 2, Tris-EDTA,pH9.0 was used for antigen retrieval. 3,Secondary antibody was diluted at 1:200(room temperature, 45min).
Immunohistochemical analysis of paraffin-embedded human liver cancer. 1, Antibody was diluted at 1:200(4° overnight). 2, Tris-EDTA,pH9.0 was used for antigen retrieval. 3,Secondary antibody was diluted at 1:200(room temperature, 45min).

 Manual
Manual